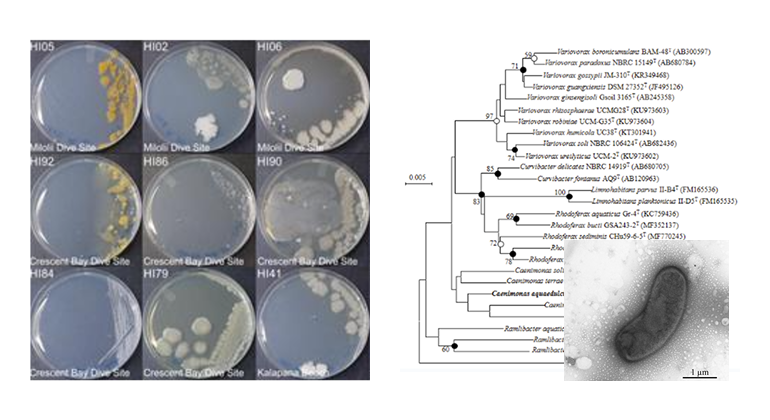

참여기관 소개
연구책임자의 전문 분야 및 대표실적
오믹스를 대표하는 연구책임자의 전문분야 및 대표실적을 소개합니다.

미생물 오믹스 + 생태 모델링
안치용
한국생명공학연구원
- SCI급 논문 159편
- h-index: 38
- 특허등록 62건
- 기술이전 9건
- 신기술 인증 2건
- 2021년 14회 여천생태학상 수상
- 2024년 과기정통부 장관 표창장 수상
미세조류 오믹스
기장서
상명대학교
- SCI급 논문 195편
- SCOPUS h-index: 42
- 특허등록 4건
- 국가RND 25건 수행
- Toxins (IF 4.2) 편집위원
- 2018년 11회 여천생태학상 수상
- 2023년 제2회 구양 환경생물학상 수상
무척추동물/어류오믹스
이재성
인천대학교
- SCI급 논문 219편
- SCOPUS h-index: 38
- 특허등록 2건
- Ecotoxicol. Environ. Safe. (IF=6.8) 편집위원
- Mol. Cell. Toxicol. (IF=1.4) 부편집장
- 황해연구소 연구소장
건강성 평가 + 현장조사
배대열
(주)한국생태네트워크
- SCI급 논문 3편
- SCOPUS h-index: 3
- 특허등록 1건
- 수생태 건강성평가 기법 개발(총 2건, 하천+호소)
- 하천수생태건강성(08~현재)
- 하구수생태건강성(17~현재)
- 호소생태조사(총 5건)
KRIBB
선행 연구 및
보유 핵심 기술
보유 핵심 기술
미생물 신종 분리, 유전체 연구
1
미생물 신종 분리
- IJSEM 논문 33편
- Anton Leeuw 논문 6편
2
미생물 유전체 분석

녹조 원인종 Microcystis 국내 최초 genome sequencing (환경부 차세대핵심환경기술개발사업)
3
미생물의 활용

Le et al. 2023. J. Clean. Prod. (IF 10.0)
미생물 네트워크 및 전사체
1
녹조 발생/사멸에서의 미생물 상호작용 네트워크

Chun et al. 2020. Wat. Res. (IF 12.4)
2
녹조 발생 기여 미생물 군집의
특성 분석
특성 분석

Le et al. 2023. Sci. Tot. Environ. (IF 8.0)
3
전사체 분석에 의한 살조 기작 규명

Kim et al. 2025. Harmful Algae (IF 4.5)
수생태 모델링 및 생태정보학
1
딥러닝 기반 유해조류 발생 모델링

Kang et al. 2024. J. Environ. Manage. (IF 8.4)
2
수생태 미생물에 대한 오믹스 분석

Le et al. 2024. Sci. Tot. Environ. (IF 8.0)
3
미생물 군집에 대한 환경 요인의 영향 분석

Kang et al. 2024. Sci. Tot. Environ. (IF 8.0)
| NO | 실적 |
|---|---|
| 1 | Le VV, Ko SR, Kang M, Oh HM, and Ahn CY. 2022. Mucilaginibacter aquariorum sp. nov., isolated from fresh water. J. Microbiol. Biotechnol. 32: 1553-1560. |
| 2 | Ko SR, Le VV, Kang M, Oh HM, and Ahn CY. 2023. Mucilaginibacter straminoryzae sp. nov., isolated from rice straw used for growing periphyton. Int. J. Syst. Evol. Microbiol. 73: 005714. |
| 3 | Le VV, Ko SR, Kang M, Shin Y, Lim B, Kang YH, Oh HM, and Ahn CY. 2023. Periphyton reduces cyanobacterial blooms by promoting potentially cyanobactericidal bacteria. J. Appl. Phycol. 35: 1285-1299. |
| 4 | Kang M, Le VV, Ko SR, Lee SA, Choi DY, Oh HM, and Ahn CY. 2023. Novosphingobium cyanobacteriorum sp. nov., isolated from a eutrophic reservoir during the Microcystis bloom period. Int. J. Syst. Evol. Microbiol. 73: 006042. |
| 5 | Le VV, Kang M, Ko SR, Jeong S, Park CY, Lee JJ, Choi IC, Oh HM, and Ahn CY. 2023. Dynamic response of bacterial communities to Microcystis blooms: a three-year study. Sci. Total Environ. 902: 165888. |
| 6 | Le VV, Ko SR, Kang M, Jeong S, Oh HM, and Ahn CY. 2023. Comparative genome analysis of the genus Curvibacter and the description of Curvibacter microcysteis sp. nov. and Curvibacter cyanobacteriorum sp. nov., isolated from fresh water during the cyanobacterial bloom period. J. Microbiol. Biotechnol. 33: 1428-1436. |
| 7 | Le VV, Ko SR, Oh HM, and Ahn CY. 2023. Genomic insights into Paucibacter aquatile DH15, a cyanobactericidal bacterium, and comparative genomics of the genus Paucibacter. J. Microbiol. Biotechnol. 33: 1615-1624. |
| 8 | Le VV, Kang M, Ko SR, Park CY, Lee JJ, Choi IC, Oh HM, and Ahn CY. 2024. Response of particle-attached and free-living bacterial communities to Microcystis blooms. Appl. Microbiol. Biotechnol. 108: 42. |
| 9 | Le VV, Ko SR, Kim MS, Kang M, Jeong S, and Ahn CY. 2024. Sphingobium cyanobacteriorum sp. nov., isolated from fresh water. Int. J. Syst. Evol. Microbiol. 74: 006339. |
| 10 | Kang M, Le VV, Ko SR, Chun SJ, Choi DY, Shin Y, Kim K, Baek SH, and Ahn CY. 2024. Effect of rainfall in shaping microbial community during Microcystis bloom in Nakdong River, Korea. Sci. Total Environ. 928: 172482. |
| 11 | Le VV, Ko SR, Shin Y, Kim K, and Ahn CY. 2024. Succession of particle-attached and free-living bacterial communities in response to microalgal dynamics induced by the biological cyanocide paucibactin A. Chemosphere 358: 142197. |
| 12 | Le VV, Tran QG, Ko SR, Oh HM, and Ahn CY. 2024. Insights into cyanobacterial blooms through the lens of omics. Sci. Total Environ. 934: 173028. |
| 13 | Le VV, Ko SR, Nguyen LTT, Kim JC, Shin Y, Kim K, and Ahn CY. 2024. Undibacterium cyanobacteriorum sp. nov., an auxin‑producing bacterium isolated from fresh water during cyanobacterial bloom period. Antonie van Leeuwenhoek 117: 99. |
| 14 | Kang M, Kim DK, Le VV, Ko SR, Lee JJ, Choi IC, Shin Y, Kim K, and Ahn CY. 2024. Microcystis abundance is predictable through ambient bacterial communities: A data-oriented approach. J. Environ. Manage. 368: 122128. |
| 15 | Kang M, Jeong S, Ko SR, Kim MS, and Ahn CY. 2024. Biotechnological approaches for suppressing Microcystis blooms: insights and challenges. Appl. Microbiol. Biotechnol. 108: 466. |
| 16 | Le VV, Ko SR, Lee SA, and Ahn CY. 2024. Flavobacterium nakdongensis sp. nov., isolated from fresh water during the cyanobacterial bloom period. J. Microbiol. Biotechnol. 34: 2245-2251. |
| 17 | Ko SR, Le VV, Lee SA, Baek SH, and Ahn CY. 2025. Algicidal effects of Fictibacillus sp. 5A8M on Margalefidinium polykrikoides through attachment and secretion of extracellular metabolites. Harmful Algae 142: 102794. |
| 18 | Kim MS, Jeong S, Kang M, Ko SR, Le VV, Choi DY, and Ahn CY. 2025. Roseateles microcysteis sp. nov., isolated from co-cultivation of Microcystis aeruginosa and Myriophyllum spicatum. Curr. Microbiol. 82: 11. |
| 19 | Jeong S, Le VV, Ko SR, Kang M, Kim MS, Li Z, and Ahn CY. 2025. Selective cyanobactericidal activity of Nocardioides convexus MS16 against Microcystis aeruginosa, mediated by direct attack. Algal Res. 90: 104165. |
| 20 | Kim MS, Ko SR, Kang M, Jeong S, Lee H, Shin Y, Kim K, Ahn CY. 2025. Growth inhibition of harmful cyanobacterium Microcystis by picocyanobacterium Cyanobium: transcriptome-based interaction analysis. Harmful Algae 148: 102923. |
| 21 | Kang M, Jeong S, Le VV, Ko SR, Kim MS, Choi DY, and Ahn CY. 2025. Ferrovibrio plantarum sp. nov., Isolated from the Co‑culture of Myriophyllum spicatum (Water Milfoil) and Microcystis aeruginosa. Curr. Microbiol. 82: 424. |
01
마이크로시스티스 에루지노사에 대한 살조활성을 가지는 노카르디오이데스 컨벡서스 균주 및 이의 용도(2024.04.16. 출원번호 10-2024-0050962)
02
마이크로시스티스 에루지노사에 대한 살조활성을 가지는 크로모박테리움 리조리제 균주 및 이의 용도(2024.12.19. 출원번호 10-2024-0191254)
| NO | 실적 |
|---|---|
| 1 | UST 연구논문상 우수상(르반베, 2022.12.21, 과학기술연합대학원대학교(UST)) |
| 2 | UST 연구논문지도상 우수상(안치용, 2022.12.21, 과학기술연합대학원대학교(UST)) |
| 3 | UST 총장상(르반베, 2023.02.28, 과학기술연합대학원대학교(UST)) |
| 4 | 포스터발표상 우수(고소라, 정선아, 2023.04.21, 한국환경생물학회) |
| 5 | 신진연구자 구두발표상(르반베, 2023.04.21, 한국환경생물학회) |
| 6 | UST 우수교수상 최우수상(안치용, 2023.12.20, 과학기술연합대학원대학교(UST)) |
| 7 | 표창장(안치용, 2024.03.08, 과기정통부장관) |
| 8 | 우수발표논문상(이하영, 2025.03.21, 한국생태학회) |
| 9 | Best 포스터상(이하영, 2025.05.30, Asia Symposium on Microbial Ecology) |
상명대학교
선행 연구 및
보유 핵심 기술
보유 핵심 기술
조류 분리, 첨단 무균배양, 바코딩
1
미세조류 신속, 신종, 미기록종 분리

- Phytotaxa (IF 1.0) SCIE 4편
- 한국미생물학회지 논문 8편
2
미세조류 첨단 무균배양법 개발

담수 와편모조류 Peridinium bipes 분리 및 첨단
무균 배양 유도 (J. Fresh. Ecol. 2005, IF 1.4)
무균 배양 유도 (J. Fresh. Ecol. 2005, IF 1.4)
3
미세조류 메타게노믹스(바코딩) 생물다양성

Diversity, Mar.Freshw.Res., Pol.Biol, J. Oceano 등 SCIE저널에 6편 발표
미세조류 전사체, 유전체 분석
1
와편모조류 전사체 비교 및 독소 유전체 특성

Wang et al. 2020. Harmful Algae (IF 4.5)
2
전사체 분석에 의한 삭시톡신 합성 차이 규명

Wang et al.
2020. Ecotox.Environ.Safe. (IF 6.1)
2020. Ecotox.Environ.Safe. (IF 6.1)
3
와편모조류 게놈 시퀀싱 및 고유 특성 규명

Ponmani et al. 2016. J. Appl. Phycol. (IF 3.0)
조류 바이오마커 발굴 기술
1
미세조류 독소 관련 바이오마커 특성 규명

Wang et al. 2022. Sci. Total Environ. (IF 8.0)
2
오염물질에 대한 조류 바이오마커 반응 규명

Wang et al. 2018. Chemosphere (IF 8.1)
3
담수 조류 CuZnSOD 바이오마커 특성 분석

Wang & Ki 2020. Environ. Toxicol. (IF 3.2)
| NO | 실적 |
|---|---|
| 1 | Bui QTN, Kim HS, Ki JS (2022) Low salinity causes oxidative stress and modulates specific antioxidant gene expression in the toxic dinoflagellate Alexandrium pacificum. Journal of Applied Phycology, 34(5), 2437-2447. |
| 2 | Bui QTN, Ki JS (2023) Two novel superoxide dismutase genes (CuZnSOD and MnSOD) in the toxic marine dinoflagellate Alexandrium pacificum and their differential responses to metal stressors. Chemosphere, 313, 137532. |
| 3 | Lee YS, Kim T, Kim, Muhammad BL, Ki JS (2023) Comparison of the phytoplankton community compositions between the temperate reservoir and the downstream river areas of the Han River, Korea. Journal of Freshwater Ecology, 38, NO. 1, 2205874. |
| 4 | Lee HE, Kim T, Lee SD, Ki JS (2023) Description of an unrecorded diatom Fragilaria saxoplanctonica Lange-Bertalot & Ulrich (Bacillariophyceae) from Paldang Reservoir in Korea. Journal of Species Research 12(4), 313-320. |
| 5 | Park H, Kim HS, Abassi S, Bui QTN, Ki JS (2024) Two novel glutathione S-transferase (GST) genes in the toxic marine dinoflagellate Alexandrium pacificum and their transcriptional responses to environmental contaminants. Science of the Total Environment, 915, 169983. |
| 6 | Wang H, Wu P, Xiong L, Kim HS, Kim JH, Ki JS (2024) Nuclear genome for dinoflagellates: size variation and insights into evolutionary mechanism. European Journal of Protistology, 93, 12606. |
| 7 | Wang H, Wu P, Li F, Shin J, Ki JS (2024) and its putative function against abiotic stresses. European Journal of Protistology, 95, 126111. |
| 8 | Bui QTN, Kim T, Kim HS, Lee S, Lee S, Ki JS (2024) Sub-lethal effects of metals and pesticides on the freshwater dinoflagellate Palatinus apiculatus and environmental implications. Water Environment Research, 96(9), e11128. |
| 9 | Kim T, Pradhan B, Ki JS (2024) Staining to machine learning: An emerging technology for determination of microalgal cell viability. Journal of Applied Phycology, 36(5) 2573–2592. |
| 10 | Bui QTN, Kim T, Kim HS, Ki JS (2025) Defensive responses of most antioxidant genes in the freshwater dinoflagellate Palatinus apiculatus to cadmium stress and their implications. Ecotoxicology and Environmental Safety 289, 117380. |
| 11 | Lee HE, Kim T, Ki JS (2025) Description of Mychonastes koreanus sp. nov. (Sphaeropleales, Chlorophyceae) isolated from the Yun River, Republic of Korea: Description of Mychonastes koreanus sp. nov. from Korea. Phytotaxa 693 (4): 255–269. |
| 12 | Lee HE, Kim T, Kim HS, Lee OM, Ki JS (2025) Evaluating nuclear (18S, ITS, and 28S) and chloroplast (psbB, psbC, rbcL, and tufA) genes of the green algae Monoraphidium (Sphaeropleales, Chlorophyta) for DNA barcoding. ALGAE 40(2): 103-115. |
| 13 | Shin J, Kim HS, Bui QTN, Kim T, Ki JS (2025) Photosynthesis genes modulate cadmium tolerance in the freshwater green algae Closterium acutum revealed by transcriptome analysis. Journal of Applied Phycology, 37(3) 1951-1965. |
| 14 | Bui QTN, Kim HS, Ki JS (2025) Two chloroplast superoxide dismutase genes (MnSOD and CuZnSOD) in the freshwater dinoflagellate Palatinus apiculatus and their high-level gene expression against algicidal agents. Journal of Applied Phycology, (on-line) |
01
기장서, 박재영, 김태희 (2023.9.4) 선체를 포함한 수중구조물 표면에 붙어 있는 미소생물 채집도구 및 사용 방법. 등록번호 제 10-2576190호 (출원번호10-2022-0111558).
02
기장서, 홍진주, 김태희, 김한솔 (2025.8.19) 농약류 오염 진단을 위한 규조류 프라길라리아 유래 오메가 클래스 글루타티온 S-트랜스퍼라제 바이오마커 및 그의 용도. (출원번호 10-2025-0114652)
| NO | 실적 |
|---|---|
| 1 | 제32회 과학기술우수논문상(기장서, 2022.6.29., 한국과학기술단체총엽합회) |
| 2 | 제7회 바당조류학상(김한솔, 2022.10.20, (사)한국조류학회) |
| 3 | 미생물학회지논문상(기장서, 2022.10.31., (사)한국미생물학회) |
| 4 | MBcell 젊은과학자상(김태희, 2023.10.26, 한국미생물학회) |
| 5 | 제2회 구양환경생물학상(기장서, 2023.10.19, 한국환경생물학회) |
| 6 | 삼각박사학위논문상(김한솔, 2024.11.7, 한국해양학회) |
인천대학교
선행 연구 및
보유 핵심 기술
보유 핵심 기술
비모델생물 게놈 DB 구축/활용
1
점박이송사리 게놈 DB 구축/활용

Rhee et al. 2017. Sci. Rep. (IF 3.9)
2
황복 게놈 DB 구축/활용

Kang et al. 2020. Mol. Ecol. Resour. (IF 5.5)
3
기타 무척추동물 및 어류 게놈 DB 구축

기타 무척추동물 및 어류 총 8종 이상 게놈 DB 구축 및 현재 활용 중
무척추동물 유해성·건강성 평가
1
해상 기름오염 대상 윤충류 유해성 평가

Kim et al. 2014. Environ. Sci. Technol. (IF 11.3)
2
남극요각류 환경 변화에 따른 건강성 평가

Kim et al. 2022. Environ. Res. (IF 7.7)
3
얼음화학 반응 이용 중금속 독성 약화

Kim et al. 2022. Environ. Sci. Technol. (IF 11.3)
어류 유해성·건강성 평가
1
수환경 변화에 따른 양식어류 건강성 평가

Shin et al. 2019. Harmful Algae (IF 4.5)
Nam et al. 2020. Fish Shellfish Immunol. (IF 3.9)
Nam et al. 2020. Fish Shellfish Immunol. (IF 3.9)
2
퇴적물 유해성 평가용 in vitro 마커 개발

Jung et al. 2020. Environ. Sci. Technol. (IF 11.3)
3
다차원 통합 오믹스 분석 기반 유해성 평가

Nam et al. 2025. Aquat. Toxicol. (IF 4.3)
| NO | 실적 |
|---|---|
| 1 | Kim, B. M., Lee, Y., Hwang, J. Y., Kim, Y. K., Kim, T. W., Kim, I. N., ... & Rhee, J.-S. (2022). Physiological and molecular responses of the Antarctic harpacticoid copepod Tigriopus kingsejongensis to salinity fluctuations–A multigenerational study. Environmental Research, 204, 112075. |
| 2 | Eom, H. J., Lee, N., Yum, S., & Rhee, J.-S. (2022). Effects of extremely high concentrations of polystyrene microplastics on asexual reproduction and nematocyst discharge in the jellyfish Sanderia malayensis. Science of the Total Environment, 807, 150988. |
| 3 | Kim, B. M., Kim, B., Nam, S. E., Eom, H. J., Lee, S., Kim, K., & Rhee, J.-S. (2022). Reductive transformation of hexavalent chromium in ice decreases chromium toxicity in aquatic animals. Environmental Science & Technology, 56(6), 3503-3513. |
| 4 | Lee, S., Haque, M. N., & Rhee, J.-S. (2022). Acute and mutigenerational effects of environmental concentration of the antifouling agent dichlofluanid on the mysid model, Neomysis awatschensis. Environmental Pollution, 311, 119996. |
| 5 | Nam, S. E., Haque, M. N., Do, S. D., & Rhee, J.-S. (2023). Chronic effects of environmental concentrations of antifoulant diuron on two marine fish: Assessment of hormone levels, immunity, and antioxidant defense system. Comparative Biochemistry and Physiology Part C: Toxicology & Pharmacology, 263, 109510. |
| 6 | Haque, M. N., Nam, S. E., Lee, M., Kim, H. W., Gil, H. W., Park, H. S., & Rhee, J.-S. (2023). Chronic exposure to environmental concentrations of harmful algal bloom-forming dinoflagellates induces oxidative stress and reduces immune and hepatic functions in red seabream. Comparative Biochemistry and Physiology Part C: Toxicology & Pharmacology, 266, 109573. |
| 7 | Lee, S., Haque, M. N., Lee, D. H., & Rhee, J.-S. (2023). Comparison of the effects of sublethal concentrations of biofoulants, copper pyrithione and zinc pyrithione on a marine mysid-A multigenerational study. Comparative Biochemistry and Physiology Part C: Toxicology & Pharmacology, 271, 109694. |
| 8 | Do, S. D., Haque, M. N., Kim, J., Im, D. H., & Rhee, J.-S. (2024). Acute and chronic effects of triclosan on the behavior, physiology, and multigenerational characteristics of the water flea Moina macrocopa. Comparative Biochemistry and Physiology Part C: Toxicology & Pharmacology, 276, 109810. |
| 9 | Kim, J., Lee, S., Jung, J. H., Kim, M., & Rhee, J.-S. (2024). Detrimental effects of hull cleaning wastewater on oxidative status, life cycle parameters, and population growth of the monogonont rotifer Brachionus manjavacas. Marine Pollution Bulletin, 200, 116121. |
| 10 | Lee, S., Nam, S. E., Jung, J. H., Kim, M., & Rhee, J.-S. (2024). Hull-cleaning wastewater poses serious acute and chronic toxicity to a marine mysid—A multigenerational study. Journal of Hazardous Materials, 469, 133959. |
| 11 | Lee, S., Kim, J., Jung, J. H., Kim, M., Park, H., & Rhee, J.-S. (2024). Exposure to hull cleaning wastewater induces mortality through oxidative stress and cholinergic disturbance in the marine polychaete Perinereis aibuhitensis. Comparative Biochemistry and Physiology Part C: Toxicology & Pharmacology, 281, 109922. |
| 12 | Kim, S. A., Choi, T., Kim, J., Park, H., & Rhee, J.-S. (2024). Acute and chronic effects of the antifouling booster biocide Irgarol 1051 on the water flea Moina macrocopa revealed by multi-biomarker determination. Comparative Biochemistry and Physiology Part C: Toxicology & Pharmacology, 285, 109994. |
| 13 | Nam, S. E., Haque, M. N., Lee, S., Kim, C. H., Kim, T. H., & Rhee, J.-S. (2024). Negligible additive effect of environmental concentrations of fragmented polyethylene terephthalate microplastics on the growth and reproductive performance of Java medaka exposed to 17β-estradiol and bisphenol A. Aquatic Toxicology, 274, 107052. |
| 14 | Lee, S., Haque, M. N., Lee, D. H., & Rhee, J.-S. (2024). The Effects of Co-Exposure to Antifoulants and Microplastics on the Survival, Oxidative Status, and Cholinergic System of a Marine Mysid. Toxics, 12(9), 651. |
| 15 | Lamine, I., Chahouri, A., Rhee, J.-S., Banaoui, A., Moukrim, A., & Ait Alla, A. (2024). Unlocking the relationship between tourism and bivalve health: A comprehensive study of Donax trunculus as environmental and public health indicators in Morocco. Marine Environmental Research, 202, 106755. |
| 16 | Lee, J., Do, S. D., & Rhee, J.-S. (2025). Acute and multigenerational effects of short-chain chlorinated paraffins on the harpacticoid copepod Tigriopus japonicus. Comparative Biochemistry and Physiology Part C: Toxicology & Pharmacology, 287, 110055. |
| 17 | Do, S. D., Lee, S., Lee, D. H., Choi, M., & Rhee, J.-S. (2025). Acute and chronic detrimental effects induced by short-chain chlorinated paraffins in the marine mysid Neomysis awatschensis. Chemosphere, 371, 144069. |
| 18 | Kim, J., Do, S. D., & Rhee, J.-S. (2025). Acute and chronic effects of the short-chain chlorinated paraffins on the monogonont rotifer Brachionus manjavacas revealed by multi-biomarker determination. Ecotoxicology and Environmental Safety, 294, 118086. |
| 19 | Do, S. D., & Rhee, J.-S. (2025). Exposure to short-chain chlorinated paraffins induces mortality in marine medaka larvae through neurotoxicity and oxidative stress. Journal of Hazardous Materials, 494, 138531 |
| 20 | Lee, J., Do, S.D., & Rhee, J.-S. 2025. The complete chloroplast genome of the halophyte Tripolium pannonicum: First record for the genus. Molecular Biology Reports, 52, 607. |
| 21 | Nam, S. E., Cheon, S., Do, S. D., Lee, S., Bae, D. Y., Jeong, T. Y., ... & Rhee, J.-S. (2025). Multi-omics integration reveals underlying toxicological mechanisms of triclosan in the freshwater fish model Zacco platypus. Aquatic Toxicology, 287, 107522 |
| 22 | Shin, J. W., Kim, B. M., Lee, S. H., Kim, J., & Rhee, J.-S. (2025). Long-read sequencing reveals novel transcript diversity in Polypterus senegalus. Animal Cells and Systems, 29, 643-652 |
| 23 | Shin, J.W., Kim, B.-M., Kim, J., & Rhee, J.-S. 2025. Assembly of a high-quality Polypterus senegalus diploid genome. Genes & Genomics, 47, 1187-1197. |
| 24 | Nam, S.-E., Kim, S.-A., Jang, M.-C., Jung, J.-H., Shin, K., & Rhee, J.-S., 2026. Seasonal and antifoulant effects on microbial–metazoan interactions in biofouling communities revealed by comprehensive eDNA metabarcoding. Marine Pollution Bulletin, 222, 118884. |
| 25 | Kim, J., Do, S.D., & Rhee, J.-S., 2026. Exposure to short-chain chlorinated paraffins induces multigenerational damage by triggering neurotoxicity and oxidative stress in the water flea Moina macrocopa. Comparative Biochemistry and Physiology Part C: Toxicology & Pharmacology, 300, 110384. |
| NO | 실적 |
|---|---|
| 1 | 우수논문발표상(남상은, 2022.10.20, 한국해양생명과학회) |
| 2 | 우수논문발표상(이소명, 2022.10.25, Joint Symposium of International Conference on Toxicogenomics & International Conference on Environmental Health Sciences) |
| 3 | 우수포스터발표상(김성아, 2023.06.28, 한국해양생명과학회) |
| 4 | 우수구두발표상(이소명, 2023.06.28, 한국해양생명과학회) |
| 5 | 해랑 우수 학술상(이재성, 2023.11.07, The International Conference on Toxicogenomics) |
| 6 | SLT 동상(이소명, 2023.11.07, The International Conference on Toxicogenomics) |
| 7 | 우수포스터발표상(김성아, 2023.12.15, 한국환경유전자학회 추계학술대회) |
| 8 | 우수포스터발표상(남상은, 2023.12.15, 한국환경유전자학회 추계학술대회) |
| 9 | 우수논문발표상(남상은, 2024.09.05, The International Conference on Toxicogenomics) |
| 10 | 해랑 우수 학술상(이재성, 2024.09.05, The International Conference on Toxicogenomics) |
| 11 | SLT 장려상(이지현, 2024.09.05, The International Conference on Toxicogenomics) |
| 12 | 학술연구상(이재성, 2025.06.23, 한국해양생명과학회) |
| 13 | 우수논문발표상(남상은, 2025.06.23, 한국해양생명과학회) |
(주)한국생태네트워크
선행 연구 및
보유 핵심 기술
보유 핵심 기술
수생생물 관련 각종 R&D
1
하천의 수생태계 평가기술 개발

- 환경부 수생태계 건강성 확보 기술개발사업
- 수생태계 연속성 평가 기술
2
생물다양성 위협 외래생물 관리기술 개발

- 환경부 수생태계 건강성 확보 기술개발사업
- 위해성 평가 및 확산-변화 예측
수생태 건강성 조사 및 평가
1
호소 수생태 건강성 조사 및 평가

- 낙동강 8개 댐 생태환경조사 및 건강성 평가
- 금강수계 호소환경 및 생태조사
- 대구광역시 호소환경 및 생태조사
2
하천 수생태 건강성 조사 및 평가

- 하천 수생태계 현황 조사 및 건강성 평가
- 미호천 지류하천 수생태계 연속성 조사 평가
- 낙동강 수계 지류지천 연속성 조사 및 평가
3
보구간 및 하구 수생태 건강성 조사 및 평가

- 하구 수생태계 현황 조사 및 건강성 평가
- 낙동강 하구 수질 및 수생태계 모니터링
- 영산강 수계 보구간 수생태계 모니터링
다양한 수준의 건강성 평가
1
군집, 개체, 장기 수준의 건강성 평가

Bae et al. 2010. Ecol. Eng. (IF 4.1)
2
Fish Biomarkers of DNA Damages

Bae et al. 2019. Pol. J. Environ. Stud. (IF 1.3)
